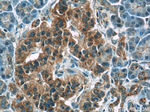
ATF6 Antibody in Immunohistochemistry (Paraffin) (IHC (P))

Search
Proteintech
ATF6 Polyclonal Antibody
{{$productOrderCtrl.translations['antibody.pdp.commerceCard.promotion.promotions']}}
{{$productOrderCtrl.translations['antibody.pdp.commerceCard.promotion.viewpromo']}}
{{$productOrderCtrl.translations['antibody.pdp.commerceCard.promotion.promocode']}}: {{promo.promoCode}} {{promo.promoTitle}} {{promo.promoDescription}}. {{$productOrderCtrl.translations['antibody.pdp.commerceCard.promotion.learnmore']}}
产品信息
24169-1-AP
种属反应
已发表种属
宿主/亚型
分类
类型
抗原
偶联物
形式
浓度
规格
纯化类型
保存液
内含物
保存条件
运输条件
产品详细信息
The fully glycosylated form of ATF6, a 670 amino acid protein, exhibits an electrophoretic mobility of ~90 kDa in denaturing SDS-gels, in part because of the glycosylated modifications. ATF6 has 3 consensus sites for N-linked glycosylation and exists constitutively as a glycosylated protein. Differentially glycosylated ATF6 forms may result from mutations or experimental treatment. The antibody recognizes cleaved and fully glycosylated forms of ATF6.
Immunogen sequence: MGEPAGVAG TMESPFSPGL FHRLDEDWDS ALFAELGYFT DTDELQLEAA NETYENNFDN LDFDLDLVPW ESDIWDINNQ ICTVKDIKAE PQPLSPASSS YSVSSPRSVD SYSSTQHVPE ELDLSSSSQM SPLSLYGENS NSLSSAEPLK EDKPVTGPRN KTENGLTPKK KIQVNSKPSI QPKPLLLPAA PKTQT (1-194 aa encoded by BC014969)
靶标信息
ATF6 is a transcription factor that acts during endoplasmic reticulum stress by activating unfolded protein response target genes. It binds DNA on the 5'-CCAC[GA]-3'half of the ER stress response element (ERSE) (5'-CCAAT-N(9)-CCAC[GA]-3') and of ERSE II (5'-ATTGG-N-CCACG-3'). Binding to ERSE requires binding of NF-Y to ERSE. ATF6 could also be involved in activation of transcription by the serum response factor. ATF6 exists as a homodimer and heterodimer with ATF6 beta. The dimer interacts with the nuclear transcription factor Y (NF-Y) trimer through direct binding to NF-Y subunit C (NF-YC). It Interacts also with the transcription factors GTF2I, YY1 and SRF. Under ER stress the cleaved N-terminal cytoplasmic domain translocates into the nucleus. The basic domain of ATF6 functions as a nuclear localization signal and the basic leucine-zipper domain is sufficient for association with the NF-Y trimer and binding to ERSE. During the unfolded protein response an approximately 50 kDa fragment containing the cytoplasmic transcription factor domain is released by proteolysis. The cleavage seems to be performed sequentially by site-1 and site-2 proteases. ATF6 is N-glycosylated, phosphorylated in vitro by MAPK14/P38MAPK and belongs to the bZIP family.
仅用于科研。不用于诊断过程。未经明确授权不得转售。
生物信息学
蛋白别名: Activating transcription factor 6 alpha; Activating transcription factor 6 beta; ATF 6; ATF6 alpha; ATF6-alpha; ATF6-beta; cAMP response element binding protein-related protein; cAMP response element-binding protein-related protein; cAMP responsive element binding protein-like 1; cAMP-dependent transcription factor ATF-6 alpha; cAMP-dependent transcription factor ATF-6 beta; cAMP-responsive element-binding protein-like 1; CREB binding serum response factor; Creb-related protein; Creb-rp; Cyclic AMP-dependent transcription factor ATF-6 alpha; Cyclic AMP-dependent transcription factor ATF-6 beta; DKFZp686P2194; FLJ21663; Protein G13; unnamed protein product
基因别名: 9130025P16Rik; 9630036G24; AA617266; AA789574; ACHM7; ATF6; ATF6A; Atf6alpha; ATF6B; ATF6beta; ATP6alpha; CREB-RP; CREBL1; ESTM49; G13
UniProt ID: (Human) P18850, (Human) Q99941, (Rat) G3V909, (Mouse) F6VAN0
Entrez Gene ID: (Human) 22926, (Human) 1388, (Rat) 304962, (Mouse) 226641, (Mouse) 12915, (Rat) 406169